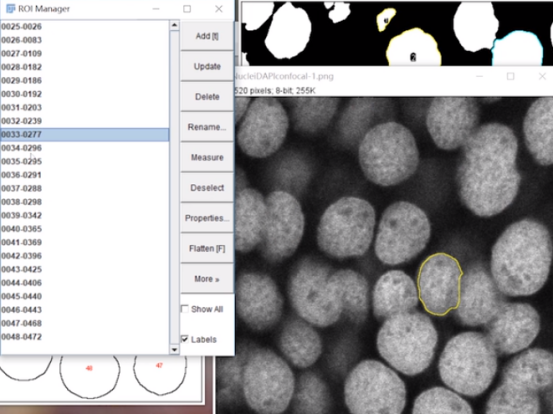

1.更改伪彩颜色
ImageJ可以打开CAI格式,尼康的2084的原始格式等等。
将图片直接拖拽到imageJ软件上。

会弹出一个窗口

这个窗口就是告诉我们:关于这个图像的原始格式是否需要进行设置。通常使用默认的,点击Ok。
就可以打开这个图像

如果打开后图像的伪彩颜色不正常怎么办?
这时可以打开Image->Color->Channels Tool

就可以设置图像伪彩颜色

Color模式:是指定显示一种伪彩颜色。

Composite:是显示多通道叠加之后的颜色。

Crayscale:显示的是灰度,不带伪彩。

Color的More里边可以更改伪彩颜色。


2.通道叠加和图像导出
通道拆分:Image->Color->Split Channel
通道合并:Image->Color->Channel Tool
图片导出:1. Image->Type->RGB Color
2. File->Save As->Tiff
通常需要有一个习惯,每次打开一张图片,把当前的图像复制一份,接下来的操作只对复制的这份进行,不会影响和更改原始图像。
在图片上点击右键,然后点击Duplicate,点击OK。


如果想得到这个图片每个单通道的图片。
通道拆分:Image->Color->Split Channel

通道合并:Image->Color->Channel Tool
图片导出:1. Image->Type->RGB Color
2. File->Save As->Tiff
当前的图是16bit的灰度图,如果想存成一张彩色图的话,需要改变图像的颜色模式。



保存Tiff


单通道保存好了,接下来存多通道的图像。

然后图片导出:1. Image->Type->RGB Color
2. File->Save As->Tiff
3.测量
测量使用的工具是Analyze->Measure
设定测量参数在Analyze->Set Measurements


Area面积、Mean gray value平均荧光强度、Min&max gray value某一区域的荧光强度最大值最小值、Centroid中心点的位置、Ferets diameter长短轴及长短轴的比值等等。
选择一个区域,可以选择的图形工具包括矩形、圆形、不规则图形等等。

矩形:
选好区域之后,点击Measure


圆形:

不规则图形:

直线:测量两点之间距离

夹角:测量角度

测量好之后,可以在Results窗口中,选择File->Save As

测量好的参数会被存成CSV格式,可以在excel里边进行数据的统计和分析。

4.自动细胞计数
步骤大概是:
Step1、图像模糊:Process->Filter->Gaussian Blur
Step2、图像分割:Image->Adjust->Threshold
Step3、精细分割:Process->Binary->File Holes
Process->Binary->Watershed
Step4、颗粒计数:Analyze->Analyze Particles
Step5、图形测量:原图->ROI Manager->Measure
首先打开一张图

进行模糊处理,使图片看起来更加平滑。
Process->Filter->Gaussian Blur


选择一个Sigma系数,Sigma系数越高,图像越模糊。

图像分割:Image->Adjust->Threshold

图像变为黑白两色。

精细分割:Process->Binary->File Holes
Process->Binary->Watershed

遗漏的孔洞会被填充上。


将没有完全分割的细胞进行分割。

颗粒计数:Analyze->Analyze Particles


图片中有一些很小的结构,这些结构可能是杂质,不是我们想要的细胞结构,我们应该过滤掉。我们可以通过识别图形的大小做一个筛选,把过小过大的去掉。
Size是通过大小过滤;
Circlarity是通过是否接近圆形来过滤;
Show是选择过滤之后图形的展示方式;
Exclude on edges是排除边缘的细胞;
Summarize是细胞个数和各种测量参数;
原图->ROI Manager->Measure

5.更改比例尺


用直线工具画在标尺上。
Analyze->Set Scale

Distance in pixels:刚刚画出的直线有多少pixels。这个不用改
Known distance:画出的这条线的真实长度是多少。
所以将Known distance改为:50,
单位Unit of Length改为:micron微米

下面有一个Scale值:2.2133pixels/micron
打开新的一张图片



两张图片的尺寸就是一样的。
添加标尺:
Analyze->Tools->Scale bar




















